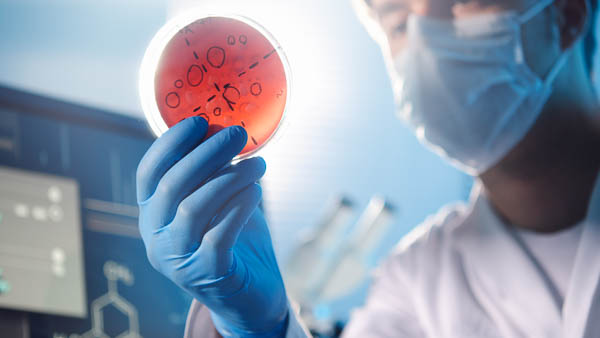

Die Formulation Software für Magier
Die Formulation Software THE DRUID bildet den gesamten Prozess der Rezepturentwicklung ab. Sie gewährleistet die sichere Erfüllung der Regulatory Affairs und der Vorgaben der Kunden. Mit der integrierten Rohstoffdatenbank, der strukturierten Verwaltung der Dokumente und der Abbildung von laborspezifischen Informationen ist THE DRUID ein echter Allrounder: zuverlässig, sicher und angenehm im Umgang.
Bei uns bekommen Sie einerseits die beste Software, andererseits die fundierteste fachliche Beratung in Sachen Prozessoptimierung. Der Wechsel zu THE DRUID erfolgt ohne viel Aufhebens. Die Auswirkung ist umso Aufsehen erregender – Sie sparen Geld, Nerven und jede Menge Zeit.

- Vielseitig: eignet sich bestens für einen Einsatz in der Kosmetik-, chemisch-technischen-, Pharma- und Nahrungsmittelindustrie
- Komplett: Rohstoffdatenbank mit regulatorischen und Tox-Daten, Verpackungen, Rezepturentwicklung, Kosten-Kalkulation, Konformitäts-Check, Chargen-Verwaltung, Bemusterungen, Produkttests, Herstellverfahren, Sicherheitsbewertung für kosmetische Mittel, Produktinformationsdatei, Dokumentverwaltung, Missing Content Mangement, Workflows, Projekt- und Task-Mangagement, Statistik- und Analysetools
- Transparent: Labor, Regulatory Affairs, Marketing, Verpackungs- und Verfahrensentwicklung sowie QS arbeiten in einer einzigen Software - von der Entwicklung im Labor bis zur Serien-Fertigung
- Bewährt: praxiserprobt und präzise wie ein Schweizer Uhrwerk
- Variabel: auf Wunsch anpassbar an Ihre Bedürfnisse
- Aktuell: ständige Weiterentwicklung und laufende Aktualisierung der Rohstoffdatenbank, beispielsweise mit regulatorischen und toxikologischen Daten
- Nahtlos: Import Ihrer Daten aus Vorgänger-Systemen oder Excel Tabellen, Schnittstellen zu Um-Systemen wie ERP
- Sicher: garantierte Datensicherheit durch Installation auf Ihren Servern und personen- sowie rollenspezifische Zugriffsrechte
- Kompetent: basiert auf jahrelangem Branchen-Knowhow, mehrjähriger Laborerfahrung und wertvollem Arbeitsprozess-Wissen
- Nachhaltig: professioneller Support mit kalkulierbaren Kosten auch nach der Einführung

- Verwaltung von Rohstoffen, Adressen, Verpackung und Produkten inkl. Dokumenten
- Rohstoff-Zusammensetzungen, Preise, Lieferanten/Hersteller, Funktionen, Wirkungen, REACH- und GHS-Daten, Chargen-Verwaltung usw.
- Missing Data Werkzeug, inkl. automatischer Email- oder Musteranfrage beim Lieferanten
- Anzeige von Warnungen, Rezepturkosten, VOC, Palmölgehalt, Naturkosmetik-Label etc.
- Historie zu Muster-Versand, -Bewertung und –Freigabe
- Einfache Erstellung von Herstellungsverfahren mit Hilfe von Phasen, Stufen, Textbausteinen für Arbeitsschritte, Warnungen etc.
- Anpassbare Labor-Einwaagelisten (Laboransätze, Pilot-Versuche etc.)
- Rezeptur-Vergleichslisten (Rohstoffe, INCI-Stoffe, prozentualen Anteile, Preis, Testergebnisse usw.)
- Anzeige des Projektstatus, filterbar nach Projekt, Kunde, Marke und Verantwortlichkeiten
- Freigabe-Workflows inkl. automatisiertem Mailversand

- Von Experten unterhaltene, ständig aktualisierte Rohstoffdatenbank mit Tox-Daten und länderspezifischen Informationen wie z.B. Restriktionen
- Konformitäts-Check für die Einhaltung von gesetzlichen, internen und Kunden-Vorgaben
- Breite Auswahl von definierbaren Qualitätskriterien wie vegan, Mikroplastik-frei, Palmöl-frei usw.
- Individuell gestaltbare INCI-Deklarationen (z.B. EU KVO, FDA usw.) nach EU/US/JP/CN-Nomenklatur mit automatischer Berücksichtigung der Allergen-Schwellwerte
- Einbezug von rohstoff- und produktspezifischen Gebrauchs- oder Warnhinweisen bei der Erstellung von Verpackungslabels
- Verwaltung von CPNP-Informationen wie Rahmenrezepturnummer, Produktkategorie, Notifizierungsnummer usw.
- Berechnung der systemischen Expositionsdosis (SED) und des Sicherheitsabstandes (MoS)
- Automatisierte Erstellung von Sicherheitsbewertungen gemäss Vorgaben der EU-Verordnung 1223/2009 unter Einbezug von toxikologischen Profilen, NOAEL/LOAEL-Werten, LD50, Verteilungskoeffizient usw.
- Individuell definierbare Inhaltsverzeichnisse für Produktinformationsdateien (z.B. für EU, ASEAN) inkl. Missing Document Management

- Chargenorientierte Verwaltung von Rohstoffen und Produktansätzen
- Führung von Rohstoff-, Produkttest-, Bulk- und Fertigwarenspezifikationen als Basis für Analysen und Tests
- Verwaltung von Prüfkriterien, Methoden und Methoden-Dokumenten
- Abbildung von internen Produkttests wie Stabilitätstests, Anwendungstests und Verpackungsverträglichkeitstest mit Einzeltestwerten und Summenbewertungen
- Dokumentation von externen Produkttests wie klinische Tests, Wirksamkeitstests und mikrobiologische Challenge-Tests inkl. Dokumente
- Individuell gestaltbare Test-Tabellen mit Prüfkriterien, Prüfintervallen und -bedingungen
- Erfassung der Testresultat-Einzelwerte in Form von Werten, Bildern oder Kommentaren
- Darstellung der Gesamtbewertung und Übersicht der Freigaben
- Direkte Vergleichsmöglichkeit von Produkttestresultaten und Bildern
- Automatische Berechnung der Produkttest-Fälligkeiten, filterbar nach Verantwortlichem, Prüfer, Produkttest-Typ usw.
- Direkter Aufruf des Tests durch Einlesen des Test-Musters mit Barcode-Scanner
- Verwendungsnachweise (z.B. wo wird ein Rohstoff oder Packmittel verwendet)
- Verschiedene Spezialsuchen (z.B. welche Produkte sind Konservierungsmittel-frei)
- Umfassende Kopierfunktionen
- Individualisierbarer Etikettendruck für Rohstoffe, Adressen, Produkt-Ansätze, Bemusterungen, Produkttests und Deklarationen inkl. Barcode
- Integriertes Meldungstool mit internen Meldungen und automatisiertem Mailversand
- Terminübersicht, Aufgabenverwaltung und persönliche Favoriten
- Standard-Schnittstelle mit ERP (z.B SAP, AXAPTA/DYNAMICS, Blending usw.) für die automatische Synchronisation von Rohstoffen, Verpackungen, Adressen, Rezeptur-Stücklisten und Verfahren
- Einbindung von MS-Office-Produkten (Word, Excel, Outlook)
- Exportierbarkeit sämtlicher Suchresultate (z.B. in Excel)
- Audit-Trail für lückenloses Dokumentieren von wichtigen Datenänderungen
- Funktionale und benutzerspezifische Berechtigungsprofile
- Standort-orientierte Datenführung
- Mehrmandantenfähigkeit
- Mehrsprachenfähigkeit
59494
Rohstoffe
10139
Restriktionen
67%
Effizienter
Feedback von Profis an Profis
Wir sind für Sie da
Kontakt
Adresse:
JOVIS enterprises ltd
Buechstrasse 21
CH-8645 Rapperswil-Jona
Telefon: +41 44 942 24 24
Mail
Koordinaten:
Google Maps